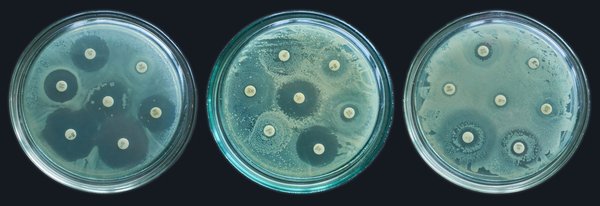
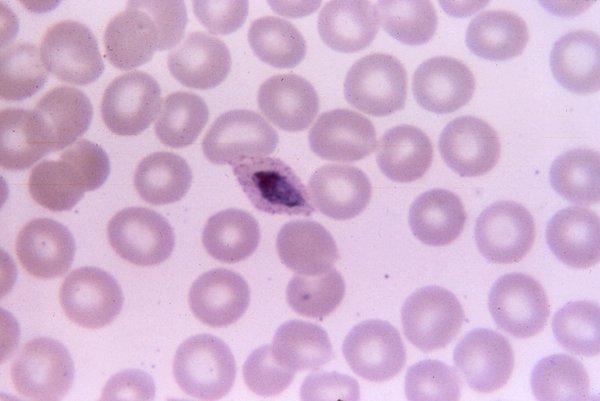

353. Aldizkaria
28 €
/urtean
2024ko Proam Astronomia Kongresua, Donostian
Astronomia
2024ko mar. 1a, 00:00
Gisella Perlen bizitza erdiragarria
Osasuna
2024ko mar. 1a, 00:00
...eta adimen artifiziala arautzeaz
Adimen artifiziala
2024ko mar. 1a, 00:00
Debagoieneko teilatuen ahalmen energetikoa
Teknologia
2024ko mar. 1a, 00:00
Mineralen eskasiaz harago
Ingurumena
2024ko mar. 1a, 00:00
Bakardadea gaitz denean
Osasuna
2024ko mar. 1a, 00:00
Antibiotikoekiko erresistentzia Osasun Bakarraren ikuspegitik
Osasuna
2024ko mar. 1a, 00:00
Antibiotikoen erabilera eta ondorioak
Osasuna
2024ko mar. 1a, 00:00
Antibiotikoekiko erresistentzia
Osasuna
2024ko mar. 1a, 00:00
Javier Aizpurua Iriazabal
“Argiaren difrakzio-muga gainditzeak erabat txundituta utzi ninduen”
Fisika
2024ko mar. 1a, 00:00
Downen sindromea eta alzheimerra
Osasuna
2024ko mar. 1a, 00:00
Zergatik dut gustuko gustuko dudana?
Osasuna
2024ko mar. 1a, 00:00
Antartikan elektrizitatea modu jarraituan sortzea lortu dute, bero geotermikoa baliatuta
Teknologia
2024ko ots. 6a, 00:00
Latxa izeneko hizkuntza-eredua sortu du HiTZ Zentroak euskararentzat
Adimen artifiziala
2024ko ots. 1a, 00:00
Alzheimerraren transmisio-bide bat deskribatu dute, kasu oso bakanetan oinarrituta
Osasuna
2024ko urt. 31a, 00:00
Mikrobiota eta gaixotasun metabolikoa
Osasuna
2024ko mar. 1a, 00:00
Mielinak garunaren energia-gordailu gisa funtziona dezakeela frogatu dute
Osasuna
2024ko urt. 26a, 00:00
Izotz-gordailu handiak aurkitu dituzte Marteko ekuatorean
Astrofisika
2024ko urt. 25a, 00:00
Duela 35.000-7.000 urte Atxurrako inguruneak izandako bilakaera ikertu dituzte
Ekologia
2024ko urt. 24a, 00:00
Maskuriko tumoreak % 90 murriztea lortu dute, nanorrobotak erabiliz
Osasuna
2024ko urt. 18a, 00:00
Rhesus makako bat klonatu dute, ohiko teknika hobetuz
Osasuna
2024ko urt. 17a, 00:00
Malariari aurre egiteko lehen hesi immunitarioa identifikatu dute
Osasuna
2024ko urt. 16a, 00:00
Itsas hondoko meatzaritza baimentzeko lehen pausoa eman dute Norvegian
Ingurumena
2024ko urt. 15a, 00:00
Alzheimerraren bost aldaera identifikatu dituzte
Osasuna
2024ko urt. 10a, 00:00
Hegazti-gripeak gutxienez hartz polar bat hil duela baieztatu dute
Ingurumena
2024ko urt. 8a, 00:00
Grafenoz egindako lehen erdieroale funtzionala lortu dute
Fisika
2024ko urt. 4a, 00:00
Muitze Zulaika Gallastegi
“Espazio hau askoz ere feministagoa izatea nahiko nuke”
Berdintasuna
2024ko urt. 5a, 00:00
Zelula fotovoltaikoen ekoizpenari mineral jakinen eskasiak nola eragingo dion aurreikusi dute
Energia berriztagarriak
2023ko abe. 26a, 00:00